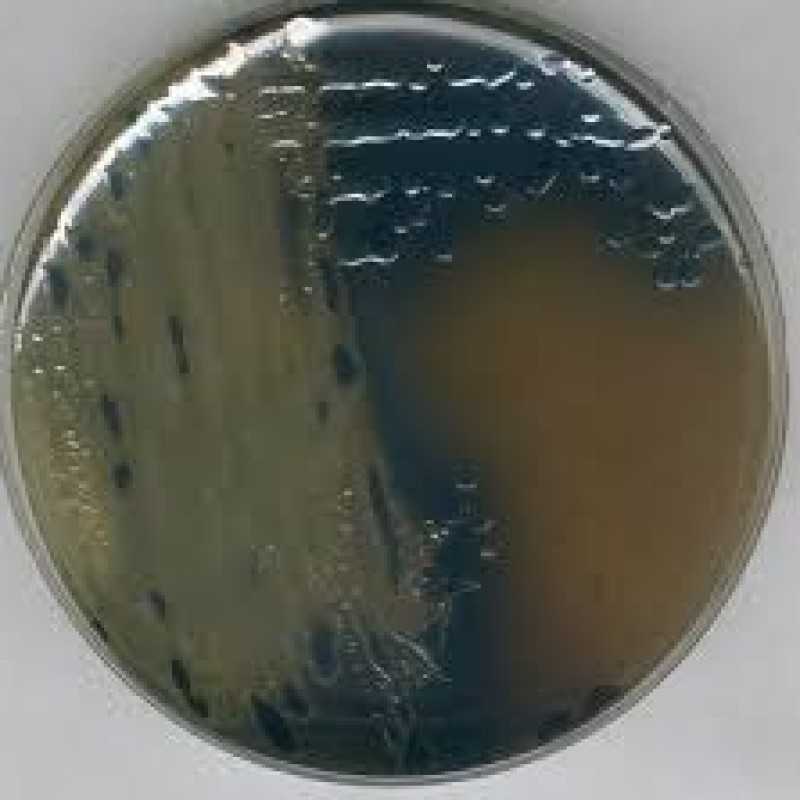

NutriSelect® Bismuth Sulfite (BS) Agar introduced by Wilson-Blair (1927) is specifically designed for the isolation and differentiation of Salmonella spp from food, animal feed and other materials precisely when the detection of Salmonella enterica subspecies enterica serovars Typhi and Paratyphi is of concern.
Colonies of H2S positive Salmonella exhibit blackening due to the formation of iron sulfide. The media selectivity is enhanced by the presence of brilliant green and bismuth sulfite which inhibit the growth of gram-positive bacteria and coliforms in the sample.
Peptone, meat extract and glucose allow good growth. Disodium phosphate acts as a buffer to maintain pH and agar is the solidifying agent.
NutriSelect® Bismuth Sulfite (BS) Agar is used to isolate and differentiate Salmonella spp. from food animal feed and other materials. The medium is used to selectively grow the species when S. typhi and S. paratyphi are expected.